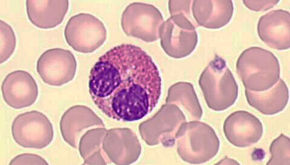

top of page
DÉCOUVREZ LES CARNETS D'ASCLÉPIOS
Le journal désabusé, parfois amusé, un tantinet comique, parfois tragique mais surtout critique d'un médecin passionné. Ces carnets sont un recueil d'anecdotes, de pensées, de souvenirs et de réflexions permettant de disséquer ce beau métier qui est le mien.

Subscribe
bottom of page